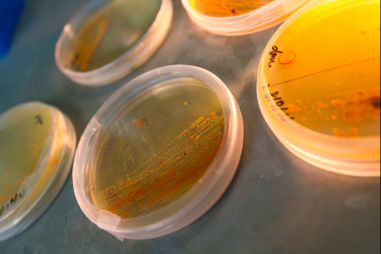
Khám phá cách phân tử trở thành vũ khí chống ung thư

Siêu bão Ragasa đi vào Biển Đông, trở thành cơn bão số 9
TNNN - Theo Trung tâm Dự báo Khí tượng Thủy văn Quốc gia, sáng 22/9, siêu bão Ragasa với cường độ cực đại cấp 16-17, giật trên cấp 17 đã tiến gần...

TNNN - Theo Trung tâm Dự báo Khí tượng Thủy văn Quốc gia, sáng 22/9, siêu bão Ragasa với cường độ cực đại cấp 16-17, giật trên cấp 17 đã tiến gần...

TNNN - Nghị quyết số 57-NQ/TW ngày 22/12/2024 của Bộ Chính trị xác định nhiệm vụ quan trọng là phải tháo gỡ vướng mắc, điểm nghẽn thể chế, đặt biệt...

TNNN - Chiều 20/12/2023, Tạp chí Tài nguyên và Môi trường tổ chức Lễ Kỷ niệm 20 năm thành lập và Ra mắt chuyên trang Tạp chí điện tử tiếng Anh.

TNNN – Tại Hội thảo Phát triển bền vững 2023 với chủ đề “Trách nhiệm của chúng ta - Hành động của chúng ta” do Báo Đầu tư tổ chức, các chuyên gia cho...
TNNN - Các nhà khoa học sau nhiều năm làm việc vất vả trong phòng thí nghiệm đã tìm ra cách đưa một vi khuẩn sinh sống ở biển tạo ra được một phân tử...

TNNN – Thỏa ước APAC-MRA góp phần mở rộng sự thừa nhận lẫn nhau về kết quả đánh giá công nhận phòng thử nghiệm và hiệu chuẩn theo tiêu chuẩn ISO/IEC...

TNNN - Nhóm các nhà nghiên cứu quốc tế phát hiện ra rằng, chỉ cần một vài đột biến, hội chứng hô hấp Trung Đông (MERS-CoV) có thể trở thành một đại...

Có nhiều lĩnh vực khác nhau trong ngành thiết kế / xây dựng, chẳng hạn như kiến trúc, thi công, kỹ thiuật, v.v. Một chuyên ngành phụ trong ngành này...

TNNN - Đây là kết luận của Phó Thủ tướng Vũ Đức Đam tại cuộc họp về định hướng nhiệm vụ của Bộ Khoa học và Công nghệ giai đoạn 2021-2025.

TNNN - Thúc đẩy hoạt động xuất khẩu hàng hóa nói chung và nông sản nói riêng là chìa khóa vô cùng quan trọng cho sự phát triển của Việt Nam.

TNNN - Chỉ với những phản ứng hóa học đơn giản, các nhà khoa học có thể biến chitin thành "siêu vật liệu".

TNNN - Cách tiếp cận mới không chỉ làm tăng thêm một trong những bằng chứng quan trọng về chất lượng không khí mà còn xác định được những “điểm nóng”...

TNNN - Hơi nước trong khí quyển cũng có thể trở thành một nguồn cấp điện tái tạo cực kỳ tiềm năng trong tương lai gần.
TNNN - Nông nghiệp hữu cơ sẽ là xu hướng tất yếu trong thời gian tới, bởi những đòi hỏi của thị trường, người tiêu dùng khiến nông dân phải tính đến...

TNNN- Với chủ đề “Nguồn lực hội tụ”, Techfest Vietnam 2019 hướng tới gắn kết, đưa Việt Nam trở thành một trong những quốc gia hàng đầu trong khu vực...

Cây bông biến đổi gen với đặc điểm hạt bông ăn được nhìn thấy trồng ở gần Belvidere, Bắc Carolina, Hoa Kỳ.